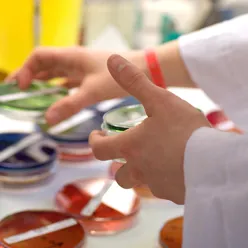
Laboratorietjenester i UNN

Laboratorietjenester
UNN har laboratorier i Tromsø, Harstad og Narvik og oppdaterer laboratoriehåndbok på nett.
Vi analyserer prøver innen mikrobiologi, patologi, medisinsk genetikk, farmakologi, medisinsk biokjemi, og immunologi og transfusjonsmedisin.
Medisinsk genetiske analyser i UNN
Her finner du nytting informasjon om løsningen, brukermanualer og kontaktinformasjon for brukerstøtte. Ønsker du å bestille løsningen, finner du også kontaktinformasjon for dette.
Elektronisk-rekvirering (helse-nord.no)
Det anbefales å benytte elektronisk rekvirering fremfor papirrekvisisjon hvis mulig.
Kortisol i spytt
For bestilling av prøvebeholdere til analysen "Kortisol i spytt", ta kontakt med laboratoriemedisin på telefon 776 26718
Fra 1. januar 2018 slås A-og B-post sammen og fremføringstiden på vanlig post blir 2 dager eller mer. I den forbindelse har Sykehusinnkjøp på vegne av alle helseforetakene inngått en avtale med Posten/Bring om forsendelse med ekspress over natt for å garantere kortest mulig transporttid for laboratorieprøver. Dette vil i all hovedsak erstatte dagens ordning, og medfører noen praktiske endringer.
I første omgang sendes det ut konvolutter, etiketter og UN3373-merke fra oss til legekontor som primært benytter UNN Tromsø. Vi ønsker at man så langt det er mulig bare har 1 forsendelse per dag, altså 1 konvolutt. Det er ikke sikkert det er mulig, og da må dere selvfølgelig sende 2.
Det betyr at alle prøver skal i samme forsendelse uavhengig av mottaker. Unntak er patologi med lang holdbarhet som fremdeles skal sendes i de vanlige brune prefrankerte konvoluttene merket Patologisk Anatomisk Avdeling.
Andre i primærhelsetjenesten og fra andre regioner bes ta kontakt med oss slik at vi kan ordne med fraktetiketter.
For fredagsforsendelser er det en egen etikett for lørdagsutkjøring. Vær oppmerksom på dette, da ekspress over natt sent fredag uten lørdagsutkjøring ikke vil komme frem før mandag.
UN3373-merket må alltid være på forsendelser med biologisk materiale. Kontroller at konvolutten er forsvarlig lukket, og forsterk denne om nødvendig med ekstra tape eller stifter. Dersom dere benytter en stor konvolutt og får mye ledig plass inni konvolutten, kan det være lurt å brette konvolutten i det den lukkes for å samle innholdet.
I praksis kan avsender benytte uansett egnet emballasje (konvolutt eller eske) innenfor gitte mål som gjelder for pakker. Pakkene må ha størrelse minimum mål 23x13x1cm og maksimum mål 60x60x120cm, samt vektgruppene 0-4kg eller 4-9kg.
Dersom dere mangler annen type konvolutter enn de vi sender ut, kan de prefrankerte konvoluttene brukes med fraktetikett klistret utenpå. Dette er kun dersom man ikke har annen emballasje. Minner om at prøvene alltid må pakkes i hylse med absorbant slik som før.
Pass på at konvolutten blir innlevert postkontor eller post-i-butikk innen fristen som gjelder: Se Posten/Brings nettside for denne fristen.
Forsendelse av prøver utenfor UNN
Se laboratoriehåndboka. UNN Tromsø videresender prøver for primærhelsetjenesten. Vurder holdbarhet og hastegrad ifht om prøven bør sendes direkte fra legekontor til mottaker utenfor UNN. For direkte forsendelse ta kontakt med aktuell mottaker for fraktetiketter evt emballasje.
Hentetjeneste
Det er ulike hentetjenester i Tromsø og Narvik for henting av prøver hos legekontorene til faste avtalte tidspunkt. Tjenesten organiseres av Laboratoriemedisin.
Hentetjeneste fredager i Troms og Harstad utgår fra 1.januar 2018, da forsendelse med ekspress over natt med lørdagsutkjøring erstatter denne. Se info over ang forsendelse av prøver.
Kontakt
Dersom noe er uklart er det bare å ta kontakt med oss på felles prøvemottak UNN Tromsø, på telefon 776 69849/776 69708 eller e-post
labmottak@unn.no
Laboratorier og fastleger kan ringe følgende nummer for å få opplyst prøvesvar. Pasienter må ta kontakt med legekontoret der de tok prøven for å få opplyst prøvesvar.
Laboratoriemedisin
Telefon 776 26718
Medisinsk genetikk
Telefon 777 98300
Mikrobiologi og smittever
Telefon 776 27010
Klinisk patologi
Telefon 776 27202
Bestilling av rekvirentkode sendes til Helse Nord IKT. Benytt vedlagte skjema ved bestilling av nye rekvirenter.
Bestillingsskjemaet sendes med e-post til:
Transfusjonsprosedyrer (transfusjonshåndboka) ved UNN
Immunologi og transfusjonsmedisin
Ring sentralbordet og be dem calle på vakthavende lege (i tidsrommet 08-16)
Medisinsk biokjemi
Vakttelefon leger 468 61 172 (betjent 08-16)
Klinisk farmakologi
Telefon 900 89 304 (betjent 08-16)
Noklus, Norsk kvalitetsforbedring av laboratorieundersøkelse har som mål at laboratorieanalyser blir rekvirerert, utført og tolket i samsvar med pasientens behov for utredning, behandling og oppfølging.
Sist oppdatert 06.06.2025